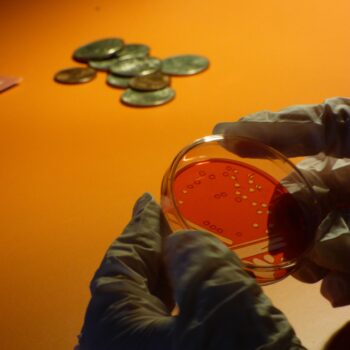

تُعتبر بكتيريا “راكدة بومانية أو Acinetobacter baumannii” واحدة من أكثر مسببات الأمراض المقاومة للمضادات الحيوية، ويُقدّر أنها تتسبب في وفاة ما بين ٥٠,٠٠٠ إلى ١٠٠,٠٠٠ شخص سنويًا. يستند هذا العمل التفاعلي إلى السيرة الذاتية والعلم ليخلق مستقبلًا قريبًا متخيلا ولكنه محتمل، مستكشفًا أسباب ومخاطر مقاومة المضادات الحيوية.
ينقل عرض “جرثومة الحرب” الجمهور إلى عام ٢٠٧٣، في زمن ما بعد “الصدع البيولوجي”، وهي الفترة التي أصبحت فيها جميع البكتيريا مقاومة لمضاداتنا الحيوية، مما أدى إلى وفاة نصف سكان الكوكب. تدور الأحداث في “متحف الآثار الطبية” المستقبلي، حيث يستكشف كيف يمكن أن تكون للحروب عواقب بيولوجية تهدد استدامة المضادات الحيوية والصحة العالمية.
يأخذنا الطبيب العراقي عمر دويشي، الذي تحول إلى عالم أنثروبولوجيا طبية، في رحلة شخصية عبر تاريخ العراق الحديث، كاشفًا كيف تطورت بكتيريا بومانية التي كانت في يوم ما بكتيريا حميدة نسبيًا لتصبح قاتلاً مثالياً، عُرف في الولايات المتحدة باسم “بكتيريا العراق” أو “العدو الخفي”. يكشف العرض التاريخ الاجتماعي المتعدد الأوجه لهذه البكتيريا من المستوى المجهري إلى الجيوسياسي، ويكشف كيف يمكن لعواقب الحرب أن تغذي مسببات الأمراض القاتلة وتهدد مستقبل الصحة والطب.
التوقيت: من الثلاثاء إلى الخميس، من الساعة 6:00 مساءً للساعة 10:00 مساءً
من الجمعة للأحد، من الساعة 2:00 مساءً للساعة 10:00 مساءً
• مشاركة: الدكتور عمر دويشي • إخراج: ياسمين فضة • كتابة: ياسمين فضة ودان دافيس • التكنولوجيا الإبداعية: غاڤين موريس وكسافيي فيلاستين • تصميم وتأليف الصوت: جيمس بولي • تصميم اللمس والرسوم البيانية: بييرانجلو بيراك وڤينشينزو سيراكوسانو • مساعدة في الإنتاج: فيسايو أديميلوي وأمايا غونزاليس • تصميم الديكور: إيزوبل باور سميث • استشارة تفاعلية وإخراج مسرحي: رايان ڤان وينكل • إنتاج: دان دافيس وبلاك ليف فيلمز • إنتاج تنفيذي: أناغرام •